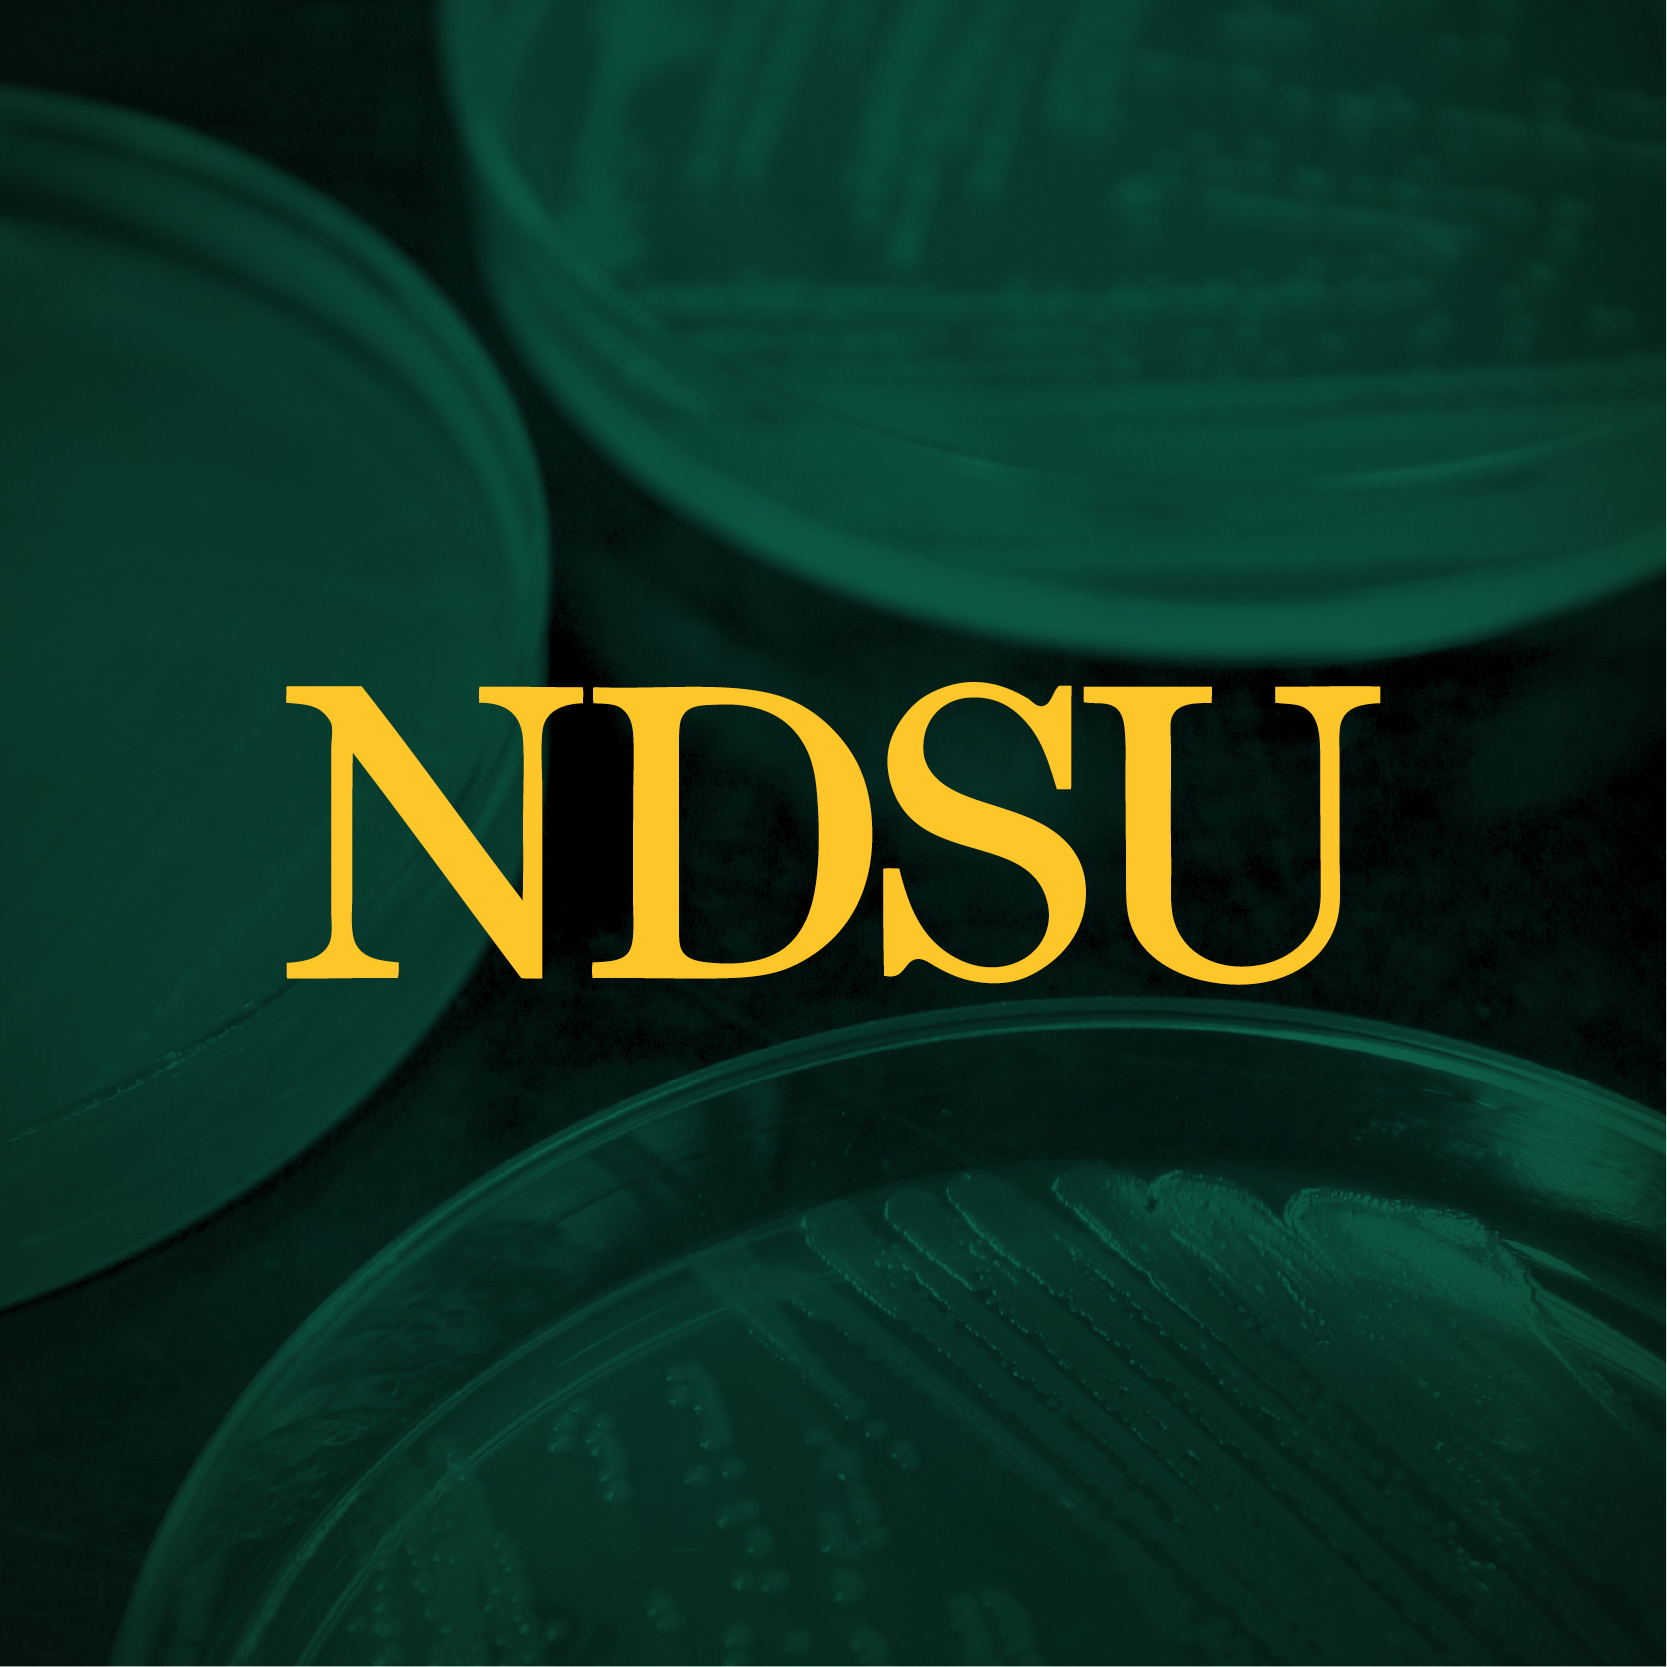

Social Media Profile Graphics
These images are intended for NDSU colleges and departments to use on their social media pages. To download, click to enlarge your chosen image, then right-click and select "Save picture as...” You can then upload it to your social media page(s) as your new profile image.